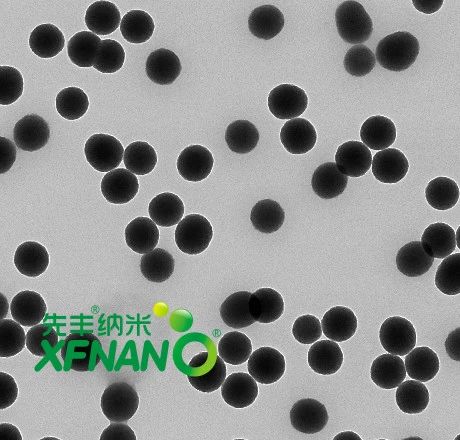
135253_206701_jswz.jpg 135253_206701_jswz.jpg

江蘇先豐納米材料科技有限公司
金牌會員
已認證

江蘇先豐納米材料科技有限公司
金牌會員
已認證
納米二氧化鈦(TiO2)
是一種重要的功能性半導體材料,迄今已廣泛應用于電子、化工、環保等領域。值得注意的是,TiO2納米粒子能夠在光激活過程中產生細胞毒性活性氧(ROS),在抗菌、抗病毒、抗癌、抗氧化和藥物輸送等生物醫學領域受到關注。
本期小豐整理了3篇TiO2納米粒子在抗菌領域的應用進展,一起看下~
Advanced Functional Materials
TiO2納米顆粒增強感染性生物膜的多模式破壞
超聲動力療法(SDT)是在聲敏劑存在的條件下,通過局部超聲產生大量的活性氧(ROS),從而起到良好的殺滅細菌的效果。然而,由于細菌生物膜的緊密保護,阻礙了 ROS 的殺菌功效。
2024年6月28日,Advanced Functional Materials報道研究人員設計了一種不對稱的鍍銀Ag并負載L-精氨酸(LA)的介孔二氧化鈦(TiO2)納米粒子Ag-TiO2-LA,以構建超聲波驅動的納米馬達滲透到生物膜深處,達到根除細菌的目的。
研究發現,Ag-TiO2-LA Janus納米粒子在超聲波激活后表現出強大的自驅力,可深入生物膜基質,并通過改善SDT效果來增強局部生物膜破壞。Ag層作為電子受體降低了Ti-O的結合能,從而促進了TiO2向Ag的電子轉移,增強了SDT效應。SDT激活后產生的ROS促使LA釋放一氧化氮,驅動納米馬達更深地穿透生物膜并有效根除,在5分鐘內實現了超過2倍的CFU計數減少。
此外,Ag的加入不僅拓寬了TiO2的吸收光譜,還在808nm近紅外激光激發下賦予了光熱功能。使用皮下膿腫模型的體內評估顯示,當采用超聲波和近紅外聯合照射時,Ag-TiO2-LA Janus納米粒子造成了顯著的CFU降低,超過1.7 logs。
Ag-TiO2-LA納米馬達將TiO2的聲動力學潛力與Ag的光熱特性結合在一起,形成了一種多功能抗菌劑,在受到近紅外和超聲波雙重刺激時,能夠高效穿透生物膜,產生協同抗菌效果。
這種結構獨特的創新型納米粒子可有效抗擊細菌生物膜,并加速生物膜的形成。
文獻名稱:Nitric Oxide‐Actuated Titanium Dioxide Janus Nanoparticles for Enhanced Multimodal Disruption of Infectious Biofilms
DOI:10.1002/adfm.202407626
Advanced Healthcare Materials
肉桂酸負載二氧化鈦納米管實現對鈦植入物的改性
骨科假體是各種終末期骨科疾病的最終治療方案。然而,無菌性松動和化膿性感染仍然是與這些器械相關的主要并發癥,找到一種有效的方法來減輕骨科植入物的無菌性和敗血性松動具有重要意義。
2024年2月17日,Advanced Healthcare Materials報道研究人員構建了一種負載肉桂醛的分層二氧化鈦納米管給藥系統,用于鈦植入物的表面改性,有望改善這個問題。
研究人員利用兩步陽極氧化工藝制備了一種獨特的分層TiO2納米管結構,并成功負載了肉桂醛。這種特殊設計的雙層二氧化鈦納米管提高了材料的反應性,并在短時間內提供了廣泛的藥物裝載平臺。與此同時,肉桂醛的加入增強了支架的骨整合性能(促進骨形成和抑制骨吸收)、抗炎能力和抗菌性能。
體外實驗表明,該系統通過上調Wnt/β-catenin和MAPK信號通路促進成骨。此外還能抑制破骨細胞的形成,降低巨噬細胞介導的炎癥反應,減少金黃色葡萄球菌和大腸桿菌的增殖。體內實驗表明,該材料可增強股骨缺損大鼠模型的骨整合,有效的增強了大鼠皮下植入模型的抗菌和抗炎特性。
該方法顯著提高了鈦種植體表面的生物活性,形成了一種多功能的生物相容性材料,能夠促進骨生成,抑制骨吸收,發揮抗炎作用,并顯示抗菌特性。
這種修飾為改善植入物的表面性能提供了一種簡單有效的方法。
文獻名稱:Multifunctional Prosthesis Surface: Modification of Titanium with Cinnamaldehyde-Loaded Hierarchical Titanium Dioxide Nanotubes
DOI:10.1002/adhm.202303374
Bioactive Materials
TiO2基復合水凝膠促進皮膚傷口愈合
皮膚傷口愈合過程是重要而復雜的,涉及止血、炎癥、細胞增殖和組織再生等多個階段。糖尿病創面和潰瘍難以愈合是目前臨床實踐中最具挑戰性的并發癥之一,甚至可能導致壞疽、截肢等。
2024年1月3日,Bioactive Materials報道了研究人員通過有機和無機活性物質的結合,制備了一種新的復合水凝膠敷料,可有效促進皮膚傷口愈合。
該團隊制備的復合水凝膠敷料(CMCS-CEBT)由羧甲基殼聚糖(CMCS)、負載外泌體的殼聚糖納米顆粒(CS-NPs)、生物活性玻璃(BG)和二氧化鈦(TiO2)組成。
殼聚糖 (CS) 具有優異的生物相容性,可加速細胞遷移、粘附和增殖。生物活性玻璃 (BG) 和二氧化鈦 (TiO2) 納米粒子釋放的離子表現出持續的血管生成和抗菌效力。
體外分析表明,該水凝膠具有良好的細胞兼容性,能刺激內皮細胞粘附和增殖,并具有抗炎、血管生成和抗菌活性。在體內,復合水凝膠敷料可加速傷口愈合,刺激血管生成,增加膠原沉積和抗炎因子的表達。
這種創新型復合水凝膠敷料利用生物活性材料,有望成為一種潛在的臨床療法,促進急性和慢性受損皮膚組織的再生。
文獻名稱:A bioactive composite hydrogel dressing that promotes healing of both acute and chronic diabetic skin wounds
DOI:10.1016/j.bioactmat.2023.12.026
先豐納米
產品推薦
XFI26 多孔二氧化鈦(介孔)

狀態:灰色粉末
孔徑 :~10 nm
粒徑:10 ~ 30nm
XFI42 二氧化鈦納米顆粒
狀態:白色分散液
粒徑:50nm,100nm,150nm,200nm,400nm,600nm,800nm,1μm
溶劑:乙醇
XFI36 二氧化鈦納米顆粒(PVP修飾)

狀態:白色分散液
粒徑:120nm,400-500nm,1.1-1.4μm
溶劑:水,乙醇
先豐納米
二氧化鈦材料匯總

相關產品
更多
相關文章
更多
技術文章
2025-10-14技術文章
2025-09-09技術文章
2025-08-26技術文章
2025-08-19
虛擬號將在 秒后失效
使用微信掃碼撥號